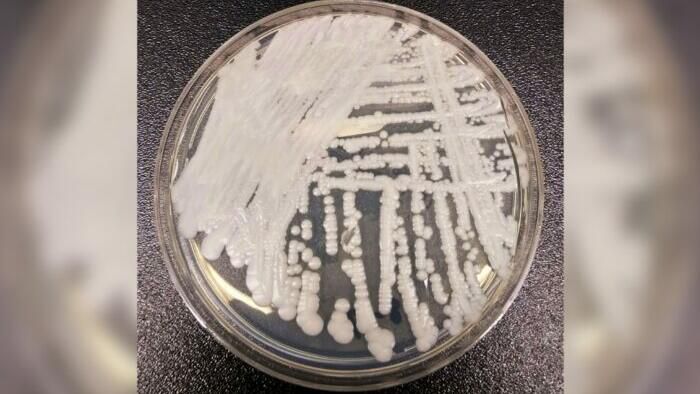

ZeroHedge News
shared a link post in group #ZeroHedge

www.zerohedge.com
CDC Warns Of Dangerous Fungal Infection Spreading Through US At 'Alarming Rate' | ZeroHedge
ZeroHedge - On a long enough timeline, the survival rate for everyone drops to zero

ZeroHedge

shared a link post in group #ZeroHedge
www.zerohedge.com
CDC Warns Of Dangerous Fungal Infection Spreading Through US At 'Alarming Rate' | ZeroHedge
ZeroHedge - On a long enough timeline, the survival rate for everyone drops to zero
Comment here to discuss with all recipients or tap a user's profile image to discuss privately.
<div data-postid="kdywov" [...] </div>